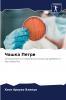
????? ?????

Russian
Paperback
₹8866
₹11469
22.7% OFF
(All inclusive*)
Delivery Options
Please enter pincode to check delivery time.
*COD & Shipping Charges may apply on certain items.
Review final details at checkout.
Looking to place a bulk order? SUBMIT DETAILS
About The Book
Description
Author
The Petri Dish A Journey Through Microbiological Time and Space:В этой работе мы исследуем увлекательную историю и эволюцию чашки Петри важнейшего элемента микробиологии. С самого начала подробно описанного в главе 1 мы узнаем о микроскопических корнях и путешествии этого прибора во времени. Мы обсуждаем ранние применения в микробиологии и бактериологии которые произвели революцию в науке с помощью этого инновационного инструмента.Глава 2 посвящена современной эпохе в которой мы анализируем его применение в пищевой промышленности фармацевтике микробной экологии и биотехнологии а также его пересечение с генной инженерией и биоинформатикой. Кроме того мы исследуем их роль в эпидемиологическом надзоре и контроле заболеваний а также их влияние на научное образование и просветительскую деятельность.Наконец в главе 3 мы рассматриваем будущее чашек Петри. Мы исследуем возникающие тенденции в области технологий автоматизации искусственного интеллекта и новых теоретических моделей. Мы рассматриваем регенеративную медицину и клеточную терапию а также этические и нормативные проблемы с которыми сталкиваются будущие микробиологические исследования.
Delivery Options
Please enter pincode to check delivery time.
*COD & Shipping Charges may apply on certain items.
Review final details at checkout.
Details
ISBN 13
9786207929092
Publication Date
-12-08-2024
Pages
-132
Weight
-190 grams
Dimensions
-152x229x7.86 mm